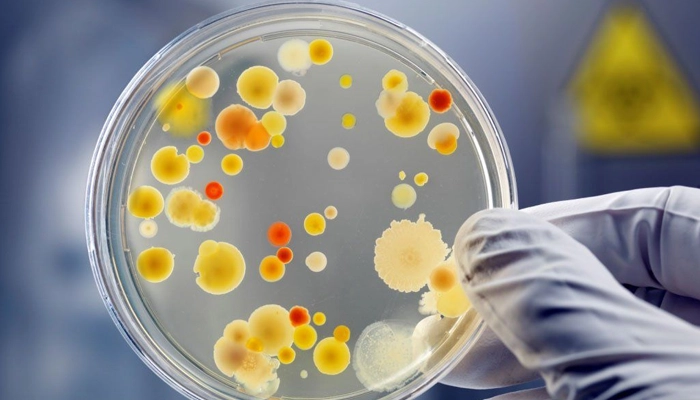

Nhiễm Nấm Phổi: Dấu Hiệu Nhận Biết Sớm Và Khi Nào Cần Đi Khám?
- 1. Nhiễm Nấm Phổi Là Gì? Nấm Xâm Nhập Phổi Bằng Cách Nào?
- 2. Nhiễm Nấm Phổi Có Nguy Hiểm Không? Mức Độ Đe Dọa Đến Tính Mạng
- 3. Dấu Hiệu Nhận Biết Sớm Nhiễm Nấm Phổi – Tránh Nhầm Lẫn
- 4. Đối Tượng Nguy Cơ Cao Nhất Bị Nhiễm Nấm Phổi
- 5. Biến Chứng Của Nhiễm Nấm Phổi Nếu Không Điều Trị Kịp Thời
- 6. Chiến Lược Chẩn Đoán Nhiễm Nấm Phổi
- 7. Khi Nào Cần Đi Khám Và Cấp Cứu?
- 8. Điều Trị Nhiễm Nấm Phổi Và Khả Năng Khỏi Bệnh
- 9. Cách Phòng Ngừa Nhiễm Nấm Phổi Hiệu Quả
- 10. Câu Hỏi Thường Gặp
- Kết Luận
Nhiễm nấm phổi (Fungal Pneumonia / Fungal Lung Infection) là một bệnh lý hô hấp nguy hiểm nhưng lại dễ bị nhầm lẫn với cảm cúm, viêm phổi thông thường. Sự mơ hồ trong Dấu hiệu nhiễm nấm phổi khiến việc chẩn đoán thường bị chậm trễ, đặc biệt ở giai đoạn đầu. Nếu không phát hiện sớm và điều trị kịp thời, bệnh có thể tiến triển nặng, gây tổn thương phổi vĩnh viễn, thậm chí đe dọa tính mạng – đặc biệt ở người có hệ miễn dịch yếu.
Bài viết chuyên sâu này được thiết kế như một cẩm nang toàn diện, giúp bạn đọc hiểu rõ Nhiễm nấm phổi là gì, phân tích chi tiết Dấu hiệu nhiễm nấm phổi mà bạn không nên bỏ qua, đối tượng nguy cơ, biến chứng, và khi nào cần đi khám để có thể xử trí kịp thời, hạn chế di chứng.
Tìm hiểu nhiễm nấm phổi là gì?
1. Nhiễm Nấm Phổi Là Gì? Nấm Xâm Nhập Phổi Bằng Cách Nào?
Nhiễm nấm phổi là tình trạng nấm xâm nhập vào đường hô hấp và gây viêm ở nhu mô phổi. Khác với virus hay vi khuẩn, nấm thường không phải là tác nhân gây bệnh chính ở người khỏe mạnh, mà chủ yếu gây bệnh khi hệ thống miễn dịch bị suy yếu.
1.1. Phân Loại Tác Nhân Gây Bệnh Thường Gặp
Các loại nấm gây bệnh phổi được chia thành hai nhóm chính:
-
Nấm Cơ Hội (Opportunistic Fungi): Thường gây bệnh ở người có miễn dịch yếu.
-
Aspergillus: Phổ biến nhất, gây bệnh aspergillosis, có thể hình thành các quả cầu nấm (Aspergilloma) hoặc dạng xâm lấn cực kỳ nguy hiểm.
-
Candida: Thường là nấm men gây nhiễm trùng huyết, sau đó lan đến phổi, gây nấm phổi do candida.
-
Pneumocystis jirovecii (PCP): Gây viêm phổi nặng, là dấu hiệu nhận biết điển hình ở người nhiễm HIV/AIDS hoặc dùng thuốc ức chế miễn dịch.
-
-
Nấm Đặc Hữu (Endemic Fungi): Gây bệnh ở cả người khỏe mạnh khi hít phải lượng lớn bào tử, phổ biến tại vùng địa lý nhất định.
-
Histoplasma, Coccidioides, Blastomyces (Phổ biến tại các vùng khí hậu nhiệt đới ẩm, châu Mỹ Latinh).
-
1.2. Con Đường Xâm Nhập Của Bào Tử Nấm
Bạn có thể hít phải bào tử nấm khi:
-
Hít bụi bẩn, đất, không khí ô nhiễm chứa nấm mốc (đặc biệt khi trời khô hanh hoặc sau mưa lớn).
-
Sống trong môi trường ẩm mốc kéo dài, các khu vực thiếu ánh sáng.
-
Tiếp xúc với chuồng trại gia cầm, phân chim (nguy cơ nhiễm Histoplasma).
-
Làm vườn, nông nghiệp, dọn dẹp các khu vực có gỗ mục, lá khô.
Sau khi vào phổi, bào tử nấm có thể nằm yên (tiềm ẩn) hoặc phát triển, gây viêm, tổn thương, thậm chí phá hủy mô phổi nếu không được điều trị kịp thời.

Aspergillus là nguyên nhân gây nhiễm nấm phổi phổ biến nhất ở người có hệ miễn dịch bình thường hoặc suy giảm nhẹ.
2. Nhiễm Nấm Phổi Có Nguy Hiểm Không? Mức Độ Đe Dọa Đến Tính Mạng
Câu trả lời là có, Nhiễm nấm phổi có nguy hiểm không tùy thuộc vào loại nấm, tình trạng miễn dịch của người bệnh và thời điểm phát hiện.
2.1. Tại Sao Nhiễm Nấm Phổi Nguy Hiểm?
Nấm phổi đặc biệt nguy hiểm vì ba lý do chính:
-
Dễ nhầm lẫn và chậm trễ điều trị: Dấu hiệu nhiễm nấm phổi ban đầu giống cảm cúm, khiến bệnh nhân thường tự ý dùng kháng sinh thông thường (vốn không có tác dụng diệt nấm). Việc điều trị sai hướng kéo dài khiến nấm có đủ thời gian để phát triển.
-
Khả năng xâm lấn mô: Một số loại nấm (như Aspergillus xâm lấn) có thể trực tiếp phá hủy các mạch máu và mô phổi, gây ho ra máu nặng, nhồi máu phổi, và tổn thương vĩnh viễn.
-
Nhiễm nấm toàn thân (Nấm huyết): Đây là biến chứng nghiêm trọng nhất. Nấm đi vào máu và lan rộng đến các cơ quan quan trọng như não, tim, gan, và thận, dẫn đến suy đa cơ quan và tỷ lệ tử vong rất cao, thường vượt quá 50%.
2.2. Tác Động Đặc Biệt Lên Người Có Hệ Miễn Dịch Yếu
Đối với nhóm nguy cơ cao (như bệnh nhân hóa trị, HIV/AIDS, hoặc sau ghép tạng), nhiễm nấm phổi cơ hội phát triển rất nhanh và cực kỳ khó kiểm soát. Chỉ trong vài ngày, bệnh có thể tiến triển từ viêm phổi khu trú thành suy hô hấp cấp hoặc nhiễm nấm toàn thân.
3. Dấu Hiệu Nhận Biết Sớm Nhiễm Nấm Phổi – Tránh Nhầm Lẫn
Dấu hiệu nhiễm nấm phổi thường biểu hiện dưới dạng các triệu chứng hô hấp và toàn thân kéo dài, không đáp ứng với điều trị thông thường.
3.1. Triệu Chứng Hô Hấp Kéo Dài (Phân biệt với cảm cúm)
-
Ho kéo dài – dấu hiệu phổ biến nhất: Ho khan hoặc ho ra đờm, kéo dài trên 2 tuần. Ho do nấm khác ho cảm cúm vì nó không giảm dù dùng thuốc ho hoặc kháng sinh thông thường.
-
Ho ra đờm trắng, vàng hoặc nâu: Gợi ý có tình trạng viêm nhiễm mạn tính tại phổi.
-
Ho ra máu: (Thường thấy trong nhiễm Aspergillus dạng xâm lấn). Đây là dấu hiệu báo động đỏ, cần cấp cứu ngay.
-
-
Khó thở hoặc thở nông: Nấm gây viêm và làm tắc các phế nang, làm giảm khả năng trao đổi oxy. Người bệnh thường cảm thấy:
-
Thở nhanh, thở nặng nhọc khi gắng sức.
-
Khó thở khi nằm, phải kê cao gối.
-
-
Đau ngực hoặc tức ngực: Cảm giác đau âm ỉ, nặng tức do mô phổi bị viêm hoặc ho nhiều gây đau vùng ngực và sau lưng.
3.2. Dấu Hiệu Toàn Thân Và Hệ Thống
-
Sốt kéo dài nhưng không rõ nguyên nhân: Sốt nhẹ đến sốt cao, có thể kéo dài dai dẳng 1–3 tuần. Đây là dấu hiệu điển hình của nhiễm trùng cơ hội mà cơ thể không thể tự giải quyết. Do kháng sinh thông thường không làm giảm sốt, vì kháng sinh không diệt được nấm.
-
Mệt mỏi kéo dài (Chronic Fatigue): Hầu hết bệnh nhân nhiễm nấm phổi mô tả tình trạng uể oải, giảm sức bền và dễ kiệt sức.
-
Sụt cân không chủ ý: Cơ thể phải “chiến đấu” với nhiễm trùng kéo dài, tiêu hao năng lượng lớn. Đây là dấu hiệu cảnh báo cần thăm khám sâu.
-
Đổ mồ hôi nhiều về đêm: Một dấu hiệu đặc trưng của nhiễm trùng hệ thống, thường bị nhầm lẫn với lao phổi.
-
Xuất hiện dấu hiệu viêm phổi nhưng điều trị không cải thiện: Nếu bạn được chẩn đoán viêm phổi vi khuẩn, đã dùng kháng sinh 5-7 ngày mà triệu chứng không đỡ, cần nghĩ đến khả năng nhiễm nấm hoặc lao phổi.

Nhiễm nấm phổi thường bị bỏ sót ở giai đoạn đầu vì triệu chứng rất giống cảm cúm, viêm phổi hoặc bệnh phổi tắc nghẽn (COPD)
4. Đối Tượng Nguy Cơ Cao Nhất Bị Nhiễm Nấm Phổi
Không phải ai cũng dễ bị nhiễm nấm phổi. Rủi ro cao nhất tập trung ở nhóm người có hệ miễn dịch yếu.
4.1. Người Có Hệ Miễn Dịch Yếu
Đây là nhóm nguy cơ cao nhất, nơi nấm cơ hội phát triển mạnh mẽ và nguy hiểm nhất:
-
Bệnh nhân ung thư: Đặc biệt là đang hóa trị hoặc xạ trị.
-
Người sau ghép tạng: Phải dùng thuốc ức chế miễn dịch suốt đời.
-
Người mắc HIV/AIDS: Viêm phổi do Pneumocystis jirovecii (PCP) là biến chứng thường gặp.
-
Người dùng Corticosteroid kéo dài: Steroid làm giảm phản ứng viêm và ức chế khả năng phòng vệ của hệ miễn dịch.
-
Người mắc bệnh tự miễn (Lupus, viêm khớp dạng thấp) phải dùng thuốc sinh học hoặc ức chế miễn dịch.
4.2. Người Mắc Bệnh Phổi Mạn Tính
Tổn thương cấu trúc phổi sẵn có tạo môi trường lý tưởng cho nấm phát triển:
-
COPD, Hen phế quản nặng: Đường thở hẹp, giảm khả năng tự làm sạch, tạo điều kiện cho bào tử nấm bám lại.
-
Giãn phế quản, Xơ phổi, Lao phổi cũ: Các hốc phổi (hang phổi, kén khí) là nơi hoàn hảo để nấm Aspergillus hình thành các quả cầu nấm (Aspergilloma).
4.3. Các Bệnh Lý Toàn Thân Khác
-
Người bị đái tháo đường: Đường huyết cao tạo môi trường giàu Glucose, giúp nấm phát triển nhanh và mạnh hơn.
-
Người già, trẻ nhỏ: Do miễn dịch yếu hoặc chưa hoàn thiện, dễ bị nhiễm nấm hơn.
4.4. Yếu Tố Môi Trường
-
Người thường xuyên tiếp xúc môi trường ô nhiễm: Công nhân xây dựng, nông dân, người làm vườn hoặc người sống trong nhà ẩm mốc.
-
Người nuôi chim, bồ câu: Phân chim là nguồn lây nhiễm Histoplasma và Cryptococcus rất nguy hiểm.

Nhận biết sớm giúp tránh biến chứng nặng và cải thiện tiên lượng.
5. Biến Chứng Của Nhiễm Nấm Phổi Nếu Không Điều Trị Kịp Thời
Nhiễm nấm phổi có nguy hiểm không được thể hiện rõ nhất qua các biến chứng sau:
5.1. Suy Hô Hấp Cấp (ARDS)
Là biến chứng nặng nhất trong phổi. Do mô phổi bị viêm và tổn thương nặng nề, phế nang bị lấp đầy dịch viêm, không thể trao đổi oxy, dẫn đến giảm oxy máu nghiêm trọng, cần phải thở máy và chăm sóc tích cực.
5.2. Tổn Thương Phổi Mạn Tính và Vĩnh Viễn
Nấm gây viêm kéo dài và làm thay đổi cấu trúc phổi:
-
Xơ phổi: Mô phổi bị xơ hóa, mất độ đàn hồi, giảm vĩnh viễn chức năng hô hấp.
-
Giãn phế quản: Đường thở bị giãn nở bất thường, dễ ứ đọng đờm, tăng nguy cơ nhiễm trùng tái phát.
-
Hang phổi: Nấm ăn mòn tạo thành các hốc (hang), làm giảm chức năng phổi và là nguồn lây nhiễm liên tục.
5.3. Nhiễm Nấm Lan Rộng (Nấm Huyết)
Nấm đi vào máu và lan tỏa đến các cơ quan khác, còn gọi là nhiễm nấm xâm lấn toàn thân (Invasive Fungal Infection):
-
Não: Gây viêm màng não do nấm, áp xe não.
-
Tim: Gây viêm nội tâm mạc, viêm cơ tim.
-
Gan, Xương, Da: Gây áp xe, tổn thương mô.
Tình trạng này yêu cầu điều trị tích cực bằng thuốc kháng nấm tĩnh mạch mạnh, nhưng tỷ lệ tử vong vẫn rất cao.
6. Chiến Lược Chẩn Đoán Nhiễm Nấm Phổi
Để chẩn đoán chính xác, bác sĩ không chỉ dựa vào Dấu hiệu nhiễm nấm phổi mà cần kết hợp nhiều kỹ thuật chuyên sâu:
6.1. Chẩn Đoán Hình Ảnh (X-quang và CT Ngực)
-
CT ngực độ phân giải cao (HRCT): Là phương pháp rõ ràng nhất, cho thấy các tổn thương chi tiết:
-
Mảng mờ phế nang, tổn thương dạng kính mờ (gợi ý PCP).
-
Tổn thương dạng nốt rải rác, đặc biệt là nốt có dấu hiệu quầng sáng (Halo Sign) (điển hình của Aspergillus xâm lấn sớm).
-
Hang phổi, hình ảnh quả cầu nấm (Aspergilloma).
-
6.2. Xét Nghiệm Huyết Thanh và Máu
-
Xét nghiệm Galactomannan / Beta-D-glucan: Đây là các xét nghiệm tìm kiếm thành phần vách tế bào nấm trong máu.
-
Galactomannan: Rất đặc hiệu cho bệnh aspergillosis.
-
Beta-D-glucan: Giúp phát hiện nhiều loại nấm khác nhau (trừ Cryptococcus và Zygomycetes).
-
-
Công thức máu, CRP, ESR: Giúp đánh giá mức độ viêm và tình trạng nhiễm trùng nói chung.
6.3. Xét Nghiệm Vi Sinh (Tiêu chuẩn Vàng)
-
Xét nghiệm đờm: Tìm bào tử nấm, nuôi cấy và định danh nấm.
-
Nội soi phế quản và Rửa phế quản phế nang (BAL): Là phương pháp xâm lấn nhưng cung cấp mẫu bệnh phẩm chính xác nhất. Dịch rửa BAL được dùng để:
-
Nhuộm soi tìm nấm.
-
Nuôi cấy và định danh.
-
Thực hiện xét nghiệm PCR tìm DNA nấm.
-
Xét nghiệm vi sinh trong nấm phổi là bước quan trọng nhất để xác định chính xác loại nấm gây bệnh
7. Khi Nào Cần Đi Khám Và Cấp Cứu?
7.1. Khi Nào Cần Đi Khám Thường Quy?
Bạn cần đi khám ngay khi có các dấu hiệu sau, đặc biệt nếu bạn thuộc nhóm nguy cơ cao:
-
Ho kéo dài trên 2 tuần không cải thiện: Đặc biệt nếu ho kèm sốt, đờm màu lạ hoặc ho ra máu.
-
Sốt dai dẳng, đã uống kháng sinh nhưng không giảm: Dấu hiệu điển hình của nhiễm nấm hoặc lao phổi.
-
Mệt mỏi, khó thở bất thường: Đặc biệt khi vận động.
-
Sống hoặc vừa tiếp xúc môi trường ô nhiễm/ẩm mốc và bắt đầu ho – sốt.
-
Người có miễn dịch yếu (đang hóa trị, dùng thuốc ức chế miễn dịch) bị ho – sốt.
7.2. Dấu Hiệu Nguy Hiểm – Cần Cấp Cứu Ngay
-
Thở gấp, co kéo lồng ngực.
-
Tím tái, SpO₂ (độ bão hòa oxy) < 92\%.
-
Lú lẫn, rối loạn ý thức.
-
Ho ra máu nhiều.
-
Mệt lả, không thể đi lại được.
8. Điều Trị Nhiễm Nấm Phổi Và Khả Năng Khỏi Bệnh
Nấm phổi có chữa được không? Có, nếu phát hiện sớm và điều trị bằng thuốc kháng nấm đặc hiệu với liều lượng và thời gian thích hợp.
8.1. Thuốc Kháng Nấm Đặc Hiệu
Điều trị phụ thuộc vào loại nấm gây bệnh và mức độ nghiêm trọng:
-
Aspergillosis: Voriconazole thường là lựa chọn hàng đầu. Trong trường hợp nặng, có thể dùng Amphotericin B.
-
PCP: Điều trị bằng Trimethoprim/Sulfamethoxazole (TMP/SMX) trong khoảng 21 ngày.
-
Candida, Histoplasma: Thường dùng Itraconazole (điều trị kéo dài) hoặc Fluconazole.
Lưu ý quan trọng: Người bệnh phải dùng đủ liều, đúng thời gian theo chỉ định của bác sĩ. Thời gian điều trị có thể rất dài, từ vài tuần đến vài tháng (đối với nấm xâm lấn).
8.2. Điều Trị Hỗ Trợ
-
Sử dụng oxy: Giúp tăng oxy trong máu và giảm gánh nặng hô hấp.
-
Điều trị bệnh nền: Kiểm soát đường huyết chặt chẽ (nếu đái tháo đường) hoặc điều chỉnh liều thuốc ức chế miễn dịch.
-
Can thiệp ngoại khoa: Trong trường hợp có quả cầu nấm lớn (Aspergilloma) gây ho ra máu tái phát, có thể cần phẫu thuật cắt bỏ một phần phổi.
9. Cách Phòng Ngừa Nhiễm Nấm Phổi Hiệu Quả
Phòng ngừa là chiến lược tốt nhất, đặc biệt cho nhóm có hệ miễn dịch yếu:
-
Giữ nhà cửa thoáng và khô ráo: Nấm mốc phát triển mạnh ở nơi ẩm thấp. Sử dụng máy hút ẩm khi cần thiết.
-
Mang khẩu trang và găng tay khi tiếp xúc với đất/bụi: Đặc biệt khi làm vườn, dọn dẹp nhà cửa, hoặc xử lý các vật liệu hữu cơ mục nát.
-
Tránh xa nguồn lây nhiễm: Hạn chế nuôi chim (bồ câu, gà) trong nhà, tránh xa các khu vực xây dựng hoặc chuồng trại.
-
Tăng cường miễn dịch: Ăn uống đủ chất, tập thể dục thường xuyên, và ngủ đủ giấc.
-
Dự phòng kháng nấm: Đối với người có miễn dịch cực kỳ yếu (như sau ghép tạng, hóa trị), bác sĩ có thể chỉ định dùng thuốc kháng nấm dự phòng theo liều thấp.
10. Câu Hỏi Thường Gặp
10.1. Nhiễm nấm phổi có lây không?
Không lây từ người sang người. Bệnh lây qua đường hít phải bào tử nấm trong môi trường.
10.2. Bệnh có chữa khỏi hoàn toàn không?
Có. Nếu được phát hiện sớm và dùng thuốc đúng phác đồ, đa số bệnh nhân có thể hồi phục hoàn toàn, đặc biệt người có miễn dịch bình thường.
10.3. Nhiễm nấm phổi có giống lao phổi không?
Không. Tuy nhiên, triệu chứng (ho, sốt kéo dài, sụt cân) rất dễ nhầm lẫn. Cần xét nghiệm tìm bào tử nấm hoặc vi khuẩn lao để phân biệt chính xác.
10.4. Nếu bị nấm phổi, tôi có phải dùng thuốc suốt đời không?
Không phải tất cả. Chỉ trong các trường hợp nấm mạn tính (ví dụ: Aspergillosis mạn tính) hoặc nhiễm nấm toàn thân ở người suy giảm miễn dịch nặng, bác sĩ mới chỉ định thuốc kháng nấm duy trì trong thời gian rất dài.
10.5. Tôi có thể chữa nấm phổi bằng thuốc Nam, thuốc Bắc không?
Không nên tự ý. Nấm phổi là bệnh lý nguy hiểm cần thuốc kháng nấm đặc hiệu, có liều lượng được kiểm soát chặt chẽ. Việc tự ý dùng thuốc dân gian có thể làm lỡ thời gian vàng điều trị.
Kết Luận
Nhiễm nấm phổi là một kẻ thù thầm lặng của hệ hô hấp, dễ gây nhầm lẫn. Việc nhận biết sớm các Dấu hiệu nhiễm nấm phổi như ho dai dẳng, sốt kéo dài không rõ nguyên nhân, và khó thở là vô cùng quan trọng.
Hãy nhớ rằng, Nhiễm nấm phổi có nguy hiểm không phụ thuộc vào khả năng miễn dịch của bạn. Nếu bạn thuộc nhóm nguy cơ cao (người có hệ miễn dịch yếu), bất kỳ triệu chứng hô hấp nào kéo dài cũng là lý do để đi khám ngay lập tức. Điều trị đúng thuốc, đủ liều và môi trường sống sạch sẽ là chìa khóa để bảo vệ phổi khỏi sự đe dọa từ nấm.
Số lần xem: 219





















